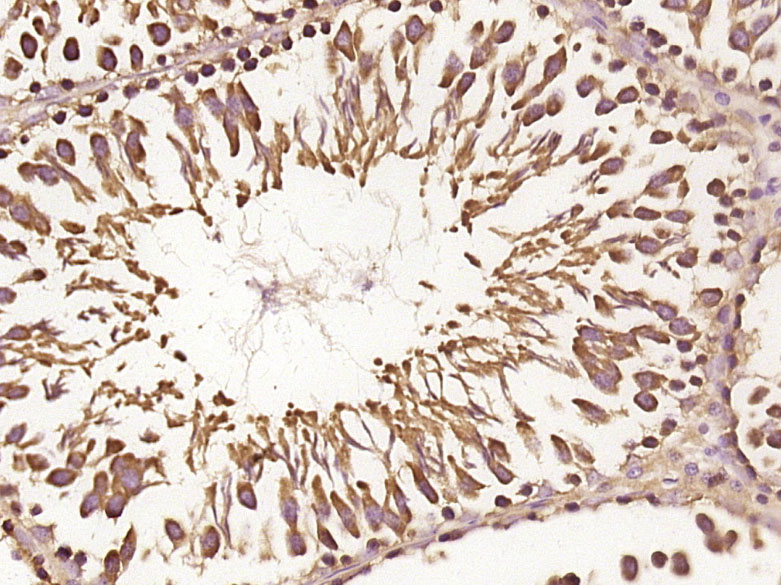

RNF170 Antibody (clone 2D6)
LS-C139257
ApplicationsWestern Blot, ELISA
Product group Antibodies
TargetRNF170
Overview
- SupplierLifeSpan BioSciences
- Product NameRNF170 Antibody (clone 2D6)
- Delivery Days Customer23
- Application Supplier NoteWestern Blot: Cell lysate, Recombinant protein.
- ApplicationsWestern Blot, ELISA
- Applications SupplierELISA, WB Western Blot: Cell lysate, Recombinant protein.
- CertificationResearch Use Only
- ClonalityMonoclonal
- Clone ID2D6
- ConjugateUnconjugated
- Estimated Purity...
- Gene ID81790
- Target nameRNF170
- Target descriptionring finger protein 170
- Target synonymsADSA; E3 ubiquitin-protein ligase RNF170; putative LAG1-interacting protein; RING-type E3 ubiquitin transferase RNF170; SNAX1
- HostMouse
- IsotypeIgG2b
- Storage Instruction-20°C or -80°C
- UNSPSC12352203